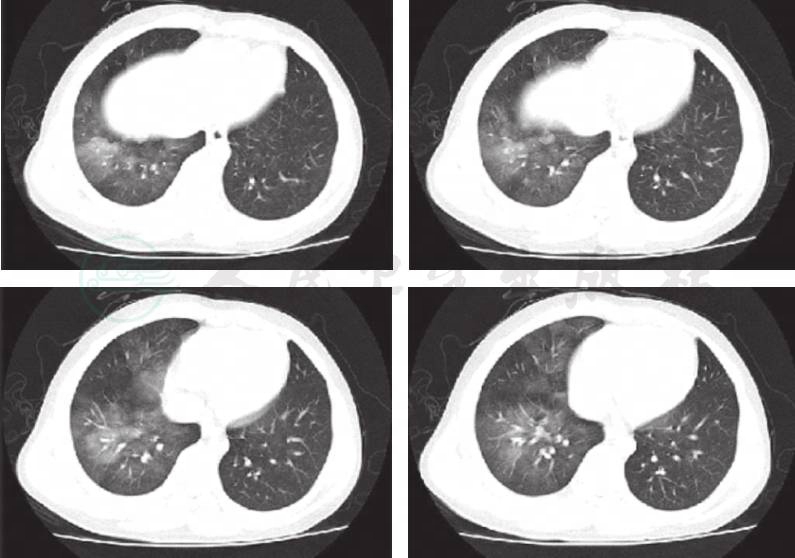

患儿,男,11岁。
主诉:间断咯血3天,呕血1次。
现病史:患儿3天前无明显诱因出现咯血,表现为咳嗽2声后咯血1次,为鲜红色伴有泡沫,每次5~8ml,约10余次,无发热,无鼻出血,无胸痛、腹痛,就诊于当地医院,给予静脉滴注消炎药(具体不详)治疗1天未再咯血出院。入院前1天患儿再次出现咯血症状,症状同前,速来笔者医院,途中患儿再次出现咯血3次,量同前,晕车后出现呕吐,呕吐物为咖啡样物,量40~50ml,就诊于笔者医院急诊,门诊以“咯血原因待查”收入笔者科室。患儿病来一般状态可,无发热,无头晕,无面色苍白,无呼吸困难,无胸痛、腹痛,无抽搐,无意识障碍,饮食、睡眠略差,饮食正常,无血尿,大便呈黑色。
既往史:约3年前出现第1次咯血,当地医院诊断为支气管扩张,咯血量较少(具体叙述不清),经抗感染治疗后症状消失出院。6个月前第2次咯血,症状同前,经抗感染治疗后症状消失出院。否认外伤及输血史。平日活动不受限,无胸痛、腹痛,无呼吸困难,无咳嗽、咳痰。
过敏及接触史:否认药物及食物过敏史。否认肝炎及肺结核、手足口病等传染病接触史。
个人史及家族史:G1P1,足月顺产第1胎,出生体重3.0kg,无牧区居住史,按时接种疫苗。否认家族遗传代谢性疾病史。否认血液系统疾病家族史。
入院查体及相关检查:神志清楚,一般状态可,呼吸平稳,周身无皮疹及出血点。面色无苍白,无鼻翼扇动及三凹征,咽略红,扁桃体Ⅱ度肿大,表面无脓苔,双肺触觉语颤正常,双肺叩诊清音,肺下界正常,双肺听诊呼吸音粗糙,未闻及干、湿啰音。心、腹及神经系统查体未见异常。
辅助检查:胸片显示(外院)双肺纹理增强。血常规:(外院)白细胞8.72×109/L;淋巴细胞百分比23.7%;中性粒细胞百分比70.4%;血红蛋白115g/L;血小板204×109/L。
入院后急检血常规白细胞正常范围,予患儿头孢甲肟预防感染,同时完善病原学及相关常规检查。次日回报TB-Ab阴性;结核抗体阴性,肺炎衣原体抗体-IgM 阴性;肺炎支原体抗体-IgM 阴性,暂无结核、肺炎支原体及衣原体感染的证据;血红蛋白92g/L,提示轻度贫血。抗核抗体、抗nRNP抗体、抗Sm抗体、抗SS-A抗体、抗dsDNA抗体均阴性;抗线粒体抗体均为阴性;抗心磷脂抗体(ACA)、抗中性粒细胞胞质抗体测定(ANCA)及抗核抗体系列(ANA)均阴性,暂不支持系统性红斑狼疮等结缔组织病和ANCA相关性血管炎等引起的肺部损害。心电图正常,心脏超声正常不支持心源性咯血。入院第2天患儿再次咯血,量同前,检查血常规提示血红蛋白进行性下降提示肺部进行性出血,立即予患儿行支气管镜检查以明确出血部位,术中发现右肺下叶基底段可见鲜血涌出(图1),予1/10 000盐酸肾上腺素局部止血。因患儿出血量较大并急行肺部增强CT扫描提示:右肺中下叶见磨玻璃密度斑片影(图2),不除外肺血管异常导致出血,立即请介入科会诊,予患儿行支气管动脉造影术,术中发现血管略增粗扭曲,另见血管瘘(图3),予明胶海绵填塞后支气管动脉栓塞良好(图4)。夜间患儿再次出现呕血1次,约为50ml鲜血,患儿血氧饱和度下降,予患儿低流量吸氧,并予患儿垂体后叶素持续静脉滴注,联合凝血酶及酚磺乙胺止血并积极补液输血纠正贫血治疗。肺灌洗液结核菌涂片阴性,PPD阴性,结合支气管镜下的改变可除外肺结核;肺泡灌洗液未查到含铁血黄素细胞不支持肺含铁血黄素沉着症。患儿共住院治疗1周,无发热,未再次咯血及活动性出血表现出院观察。出院后电话随诊,患儿出院后无再次咯血,无反复感染及咳嗽史。

图1 右肺下叶基底段可见鲜血涌出
图2 右肺中下叶见磨玻璃密度斑片影。右肺中下叶渗出病变,结合病史考虑肺泡内出血

图3 支气管动脉造影示血管略增粗扭曲,另见血管瘘

图4 透视下缓慢注入明胶海绵与少量造影剂的混悬液,再次造影见该支气管动脉栓塞良好
支气管动脉-肺动脉瘘。
诊断依据:①反复间断咯血病史;②发作时咯血量较大;③纤维支气管镜术中发现右肺下叶基底段可见鲜血涌出;④肺部增强CT扫描提示右肺中下叶见磨玻璃密度斑片影;⑤行支气管动脉造影术,术中发现血管略增粗扭曲,可见血管瘘。
大咯血是指24小时内咯血量在300~600ml。大咯血是呼吸道疾病中突然死亡的原因之一,只有5%的咯血是巨大的,一些研究报告有80%的死亡率,死亡原因主要是由于出血后窒息。最常见的病因包括支气管扩张、囊性纤维化、肿瘤、结节病、肺结核等其他感染和支气管动脉瘘所致。支气管动脉瘘患者往往具有以下特点:①发病年龄较轻,反复发生咯血,咯血量通常较大;②临床、支气管镜和CT检查均不能明确咯血的原因;③DSA检查可发现扭曲、增粗、分支增多或粗细不均的支气管动脉,并显示单发或多发的支气管动脉、肺动脉瘘。经过数十年的临床研究,支气管动脉栓塞术(BAE)已成为治疗大咯血的有效手段。
支气管动脉瘘根据引流血管的回流方向不同,可分为3种类型:①支气管动脉-肺动脉 瘘(bronchial artery to pulmonary artery shunt,AAS);② 支 气 管 动脉 -肺静 脉瘘(bronchial artery to pulmonary vein shunt,AVS);③肋间动脉 -肺动(静)脉瘘(intercostal artery to pulmonary circulation shunt,IPCS)。根据造影表现,支气管动脉-肺动脉瘘分为4型:①肺动脉主干型:表现为增粗的支气管动脉发出分支,由其毛细血管与肺门或肺动脉主干沟通,肺动脉显示清晰,大面积肺实质染色;②肺动脉毛细血管型:表现为增粗的支气管动脉发出分支,由其毛细血管与肺动脉多支毛细血管交通,形成多个瘘口,呈现“瀑布”状;③枯枝型:表现为支气管动脉增粗不明显,肺动脉显示局限;④膈动脉型:表现为异常增粗的膈动脉分支毛细血管与肺底毛细血管沟通,延迟期可见肺动脉干或左心房显影。本例进行支气管动脉造影后,发现右下肺异常染色。远端呈现“瀑布”状,考虑属于肺动脉毛细血管型。
因支气管动脉瘘患者症状不典型容易误诊为支气管Dieulafoy病,又称恒径动脉综合征,是一种以黏膜下畸形动脉破裂出血为特征的疾病。1898年,法国医生Dieulafoy首先描述该病。1995年Sweerts等第1次报道了支气管Dieulafoy病。本病多发生于成年人,既往健康或曾有咯血病史,男性似多于女性,右肺发生率高于左肺。增强CT可见支气管壁不均匀增厚,管壁有点状强化影,边界清楚,并稍向腔内膨隆;支气管镜检查镜下常见突向管腔的结节状病灶,多数搏动并不明显,易误认为肿瘤,有时因管腔内积血或血块堵塞又易漏诊。最终主要确诊手段是支气管动脉造影和手术或尸检标本病理检查,可见支气管黏膜下扩张或畸形的动脉与支气管管腔相通。
(李 淼 尚云晓)